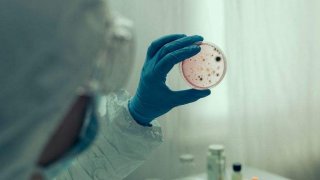

กาฬโรค

ทฤษฎีใหม่ชี้ชัด! การปะทุของภูเขาไฟในปี 1345 อาจเป็นชนวนเหตุ "กาฬโรคระบาด" ที่คร่าชีวิตชาวยุโรปเกือบครึ่งทวีป
การระบาดของ "กาฬโรค" (Black Death) ในยุคกลาง ซึ่งเกิดขึ้นในช่วงปี ค.ศ. 1348-1349 และได้คร่าชีวิตประชากรทั่วยุโรปไปเกือบครึ่งหนึ่ง ยังคงเป็นโศกนาฏกรรมครั้งใหญ่ที่นักวิชาการให้ความสนใจ และล่าสุดมีงานวิจัยทางวิทยาศาสตร์ที่น่าสนใจได้เผยเบาะแสใหม่ โดยชี้ว่า การปะทุของภูเขาไฟในช่วงปี ค.ศ. 1345 อาจเป็นจุดเริ่มต้นของปฏิกิริยาลูกโซ่ที่นำไปสู่โรคระบาดร้ายแรงที่สุดครั้งนี้ นักวิจัยจากมหาวิทยาลัยเคมบริดจ์ แล.. ดูเพิ่ม

ปริศนาความจริงข้อมูลใหม่ฉีกตำราเดิม ชี้คนแพร่เชื้อกาฬโรคไม่ใช่หนู
ปริศนาความจริงข้อมูลใหม่ฉีกตำราเดิม ชี้คนแพร่เชื้อกาฬโรคไม่ใช่หนู ข้อมูลใหม่ฉีกตำราเดิม ชี้คนแพร่เชื้อกาฬโรคไม่ใช่หนู ข้อมูลนี้อาจจะเป็นข้อมูลที่ฉีกตำราประวัติศาสตร์ที่กล่าวอ้างว่าหนูเป็นตัวแพร่เชื้อกาฬโรคแต่จริงๆแล้วหนูอาจจะเป็นสัตว์ที่ถูกใส่ร้ายเพราะว่าตัวที่แพร่เชื้อกาฬโรคคือคนนั่นเองทำใจครับ ไม่ต่างอะไรกับปลาหมอคางดำใครเป็นคนเอามาแพร่พันธุ์ในประเทศไทยขณะนี้ก็ยังไม่สามารถหาจับตัวคนกระทำผิดมาได.. ดูเพิ่ม
เด็กชาย 10 ขวบเสียชีวิตจาก 'สาเหตุที่เกี่ยวข้องกับโรคระบาด' ขณะที่เจ้าหน้าที่สอบสวนอย่างเร่งด่วน
การเสียชีวิตของเด็กชายอายุ 10 ขวบจากโคโลราโด้มีความเชื่อมโยงกับกาฬโรค เนื่องจากโรคนี้สามารถแพร่เชื้อสู่คนได้จากการถูกหมัดที่ติดเชื้อกัดหรือการจัดการกับสัตว์ที่ติดเชื้อ การเสียชีวิตอันน่าสลดใจของเด็กชายอายุ 10 ขวบเชื่อมโยงกับโรคระบาดนี้ หลังจากที่เจ้าหน้าที่สาธารณสุขเตือนว่าพวกเขากำลังตรวจสอบรายงานใหม่เกี่ยวกับการติดเชื้อแบคทีเรียในสัตว์และหมัด มีรายงานระบุว่าเด็กชาย "เสียชีวิตจากสาเหตุที่เกี่ยวข้.. ดูเพิ่ม
โรคห่า คือโรคอะไรกันแน่
โรคห่า คือกาฬโรค ยุคพระเจ้าอู่ทอง กรุงศรีอยุธยา โรคระบาดที่ทำให้คนล้มตายคราวละมากๆ คนแต่ก่อนเรียกโรคห่าทั้งนั้น ไม่ว่าจริงๆแล้วอาจล้มตายเพราะโรคมีชื่อต่างๆก็ได้ เช่น ฝีดาษ, อหิวาต์, กาฬโรค, ฯลฯ ห่า เป็นคำเรียกผีที่เชื่อว่าทำให้คนในชุมชนตายพร้อมกันคราวละมากๆต่อมาใช้เป็นคำด่าทออย่างรุนแรง เช่น ห่ากิน, ห่าแดก, ห่าลง, ห่าเหว, ฯลฯ แต่ทั่วไปใช้ว่า ไอ้ห่า, อีห่า ฝนตกคราวหนึ่งก็เรียกห่า ว่าห่าฝน ฝนตกมากเร.. ดูเพิ่ม